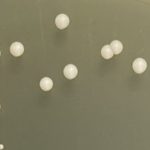
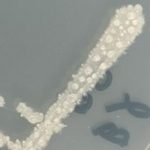
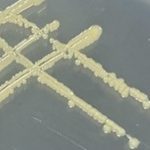

カルチャーコレクション
カルチャーコレクション
中高温微生物研究センターが保有する株のうち,分与可能なものを公開することになりました。これまで実施した拠点事業等でタイを中心とする東南アジア諸国との共同研究で分離した株やその派生株が含まれています。
当センターが保有している株については、保有株リストもしくはオンラインデータベースをご確認ください。
分与を希望される場合は分与までの流れをご確認ください。
保有株紹介
写真中の属名・種名をクリックすると説明を表示します。
Others
申込み・問い合わせ
国立大学法人山口大学 中高温微生物研究センター 事務担当
〒753-8515 山口市吉田1677-1
TEL:083-933-5246,FAX:083-933-5245
E-mail: agkenkyu( )yamaguchi-u.ac.jp ( )を@に置き換えてください。